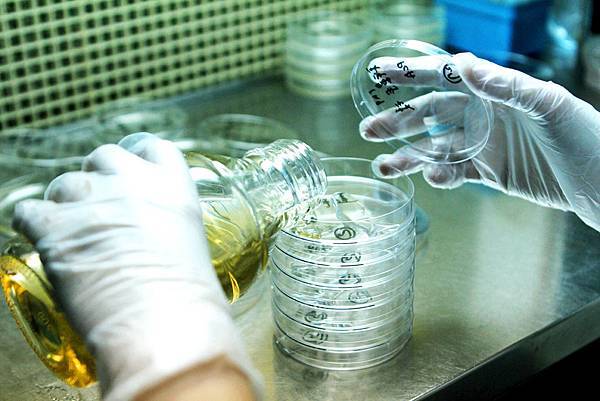
IMG_9360 IMG_9360

馬修嚴選可以很便宜....
馬修嚴選可以很便宜,但我們需要重新思考是不是不要花這麼多心思找在地友善農友,而只要便宜的水果原料就
馬修嚴選可以很便宜,但我們需要重新思考是不是不要花這麼多心思找在地友善農友,而只要便宜的水果原料就好....
馬修嚴選可以很便宜,那我們需要重新改變理念,也跟其他商人一樣,壓榨農友的利潤...
馬修嚴選可以很便宜,所以我們應該重新思考不再花這麼多心力到全世界去篩選菌種。也可以跟其他人一樣,直接買國外進口菌粉做優格...
馬修嚴選可以很便宜,只要我們改變作法,不要每年花將近百萬的檢驗費用,也不需這麼多品質管控的開銷...
馬修嚴選可以很便宜,只要用最便宜的容器裝優格、果漿就好,而不再這麼麻煩地特製保鮮盒,還要回收、回填,甚至提供回饋獎勵...
馬修嚴選可以更便宜,只要我們取消門市經營,不再免費品嚐試吃,不再有服務同仁解說,不再提供舒適的空間服務,只要網路或往貨架上一擺就行了...
馬修嚴選確可以再便宜些,只要我們引進外籍勞力,而不再堅持給台灣人就業的機會,也不需要每個月提供福利金...
馬修嚴選這些機車的行為都可以丟掉,但想要提醒的是,台灣是不是要產業升級?是不是要價值提升?是不是要邁入生活大國?是不是還要便宜又大碗...
我們相信少了馬修嚴選對台灣應該沒有影響,依然過一樣的日子,吃一樣的食物,酸一樣的新聞。但請為下一代想想,他們應該過什麼樣的日子,吃什麼樣的食物,計畫什麼樣的夢想...